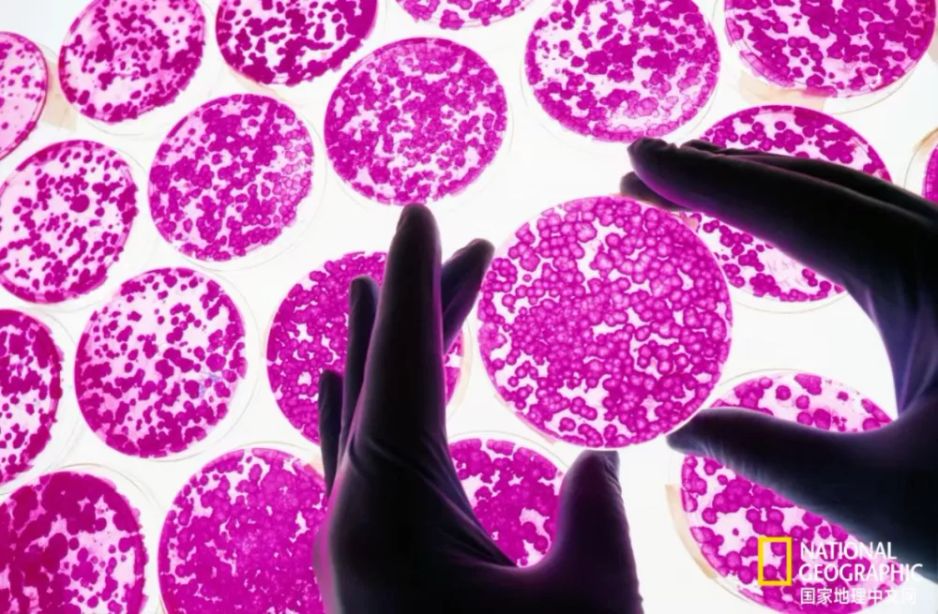
cover

手机 App 已上线
点我下载
干细胞(上图培养皿里正在生长的细胞)能够分化为人体内任何类型的细胞,包括那些能生成和修复因疾病受损组织的细胞。|国家地理图片集
1986年电影《星际迷航4:抢救未来》(Star Trek IV: The Voyage Home)中,麦考伊医生(Dr. McCoy)递给一位透析患者一颗药丸,她随即长出了新的肾脏。这正是再生医学的终极目标,但它始终难以实现。
当疾病损害心脏或肺等关键器官时,医生通常能做的最好的事不过是阻止病情恶化。如今,经过三十年的反复试验,激活人体自身干细胞、使其成为高级器官修复工厂的前景已触手可及。
干细胞是制造负责组织生长和修复细胞的关键生物工厂。加州拉霍亚(La Jolla, California)的非营利研究机构斯克里普斯研究所(Scripps Research)采用了一种新方法,利用药物扩增这些细胞。该技术已在实验室细胞、小鼠、猪和少数人类身上使死亡组织复活。与此同时,其他科学家终于通过较传统的技术取得了一些成功:在实验室对干细胞进行重新编程,然后将其植入体内以生长新组织。
如果进展如预期,这些方法有朝一日可能显著提高严重疾病患者的存活率和生活质量,其中许多疾病(如骨关节炎)与衰老有关。
大多数药物通过减缓疾病进展发挥作用,但这些新候选药物旨在修复损伤。“我们有可能在未来两到三年内证明,我们可以逆转肺损伤和心脏损伤,” 斯克里普斯研究所首席执行官兼总裁皮特.舒尔茨(Pete Schultz)说,“如果我们做到了,这将从根本上改变人们对逆转疾病的看法。”
所有相关科学家都强调,仍需在人体中进行测试以确认治疗的安全性和有效性,而且任何治疗可能需要十年时间才能获得医疗批准。但在再生医学经历了许多次失败的开端后,他们乐观地认为终于迎来了转折点。
富血小板血浆注射是目前骨关节炎的治疗选择之一。尽管这些注射可以刺激愈合,但效果因人而异。|国家地理图片集
再生医学的主要研究方向一直是从患者体内提取干细胞,对其进行处理后再重新植入患者体内。|国家地理图片集
促使天然干细胞发挥作用
在斯克里普斯研究所,这一过程始于筛选数百万潜在药物分子,以确定哪些分子能刺激器官的天然(或内源性)干细胞。研究人员发现了可增加肺、心脏、关节和眼睛中健康干细胞数量的化合物。
“这种方法既有趣又有效,” 加州大学凯克医学院(University of California’s Keck School of Medicine)伊莱和埃德yth.布罗德再生医学与干细胞研究中心(Eli and Edythe Broad Center of Regenerative Medicine and Stem Cell Research)主任查克.默里(Chuck Murry)说,他并未参与斯克里普斯的项目。默里说,斯克里普斯的技术向《星际迷航》中的著名场景迈出了一大步。
斯克里普斯的肺部药物可激活下呼吸道的干细胞,即II型肺泡细胞(type 2 alveolar epithelial, AEC2 cells),这些细胞负责制造将陈旧氧气交换为新鲜氧气的关键细胞。在健康人中,新的气体交换细胞会不断替换受损细胞,但在慢性阻塞性肺疾病、特发性肺纤维化等疾病中,或当肺部被野火烟雾或新冠病毒(COVID-19)等病毒感染损害时,这一过程会受阻。
小鼠研究表明,这种每周一次的吸入药物可刺激足够的AEC2干细胞,修复因肺纤维化(一种严重且通常致命的疾病)受损的肺部。目前,约70名健康人的安全性测试正在进行中,计划随后纳入一些肺纤维化患者。
耶鲁大学医学院(Yale School of Medicine)比较医学和遗传学助理教授毛里齐奥.乔乔利(Maurizio Chioccioli)说,使用药物刺激肺部干细胞可能会改变游戏规则,因为它可以广泛应用。“你可以想象它很容易被使用,因为人们可以吸入直接针对细胞的药物,” 乔乔利说。他自己通过对肺干细胞的实时成像研究发现,它们在修复过程中会出人意料地移动和改变形状,设计治疗方案时必须考虑这些过程。
这个实验室培育的心脏由多能干细胞制成。研究人员希望使用药物诱导心脏组织在体内再生,而非在实验室中培养。|国家地理图片集
心脏病发作后修复猪心脏
斯克里普斯的另一款药物稍晚进入研发阶段,用于在心脏病发作后重建心肌组织。如今,支架和药物可以重新打开血管并恢复血流,这一技术在近几十年将心脏病发作的死亡率降低了一半以上。
“我们显著提高了存活率,但仍有大量心肌死亡,”杜克大学(DukeUniversity)心脏病专家理查德.斯塔克(Richard Stack)说,“如果我们能让那个失去功能的区域重新开始跳动,那我们就真正有所成就了。”
斯塔克是心血管大师联盟(Cardiovascular Masters Consortium)的管理合伙人,这是一家由顶尖医生组成的咨询公司,正与斯克里普斯合作开发该药物。
这种药物是一种氢凝胶,在心脏病发作数天后注射到心肌周围的囊中,它会激活一种蛋白质通路,而这种通路在心脏达到成年大小后通常会处于休眠状态。新激活的干细胞会生成健康细胞,填充心脏受损区域。
斯克里普斯称,该药物在实验小鼠和少数猪身上有效,尽管结果尚未发表且未经过同行评审。一头猪的成像显示,其射血分数(衡量心脏向身体泵送富氧血液能力的关键指标)在心脏病发作后骤降,但在治疗一个月后恢复正常。更多猪的测试正在进行中,人体试验预计于2027年开始。
斯塔克对早期动物实验结果“惊叹不已”。“在44年的从医经历中,我从未见过如此惊人的结果,” 他说。
传统技术取得成功
与此同时,默里和他在南加州大学(University of Southern California)的同事正在对成人血液干细胞进行重新编程,使其成为心肌细胞,然后进行移植。经过数十年的断断续续的进展,这种方法终于奏效了。“我们正在心脏中制造新的肌肉,改善心脏功能;科学依据就在那里,” 默里说。
该技术已在小鼠、大鼠、豚鼠、非人类灵长类动物(nonhuman primates)和猪身上进行了测试,人体试验预计于2027年开始。“我有合理的依据说,我们已经克服了所有主要障碍,” 默里说。
最后一个障碍是,在恒河猴中,新细胞在移植后的头几个月跳动过快,引发心悸。给动物服用调节心律的药物,或者在植入前对细胞进行基因编辑(gene editing),解决了这个问题。
在2024年7月发表的一项研究中,两只猴子在心脏病发作后接受治疗,顺利接受了新细胞,没有出现任何意外,它们的心脏跳动得就像从未受过伤一样。
再生医学过去和未来的障碍
与传统技术一样,使用药物刺激人体天然干细胞的方法也并非没有挫折。斯克里普斯还试图针对干细胞生成新的关节软骨来治疗骨关节炎,但该药物在最后阶段遇到了障碍。
未发表的研究显示,这种药物在动物模型中通过诱导干细胞制造新的关节组织被证明是有效的。但在早期临床试验(clinical trial)中,将药物注射到60人的膝盖中并未产生足够数量的软骨,无法产生有意义的效果。斯克里普斯已暂停进一步研究,直到开发出更持久的配方。
诺华也在测试一种刺激软骨再生的药物,已成功完成了一项针对约24名患者的小型安全性研究。该公司正在对更多人进行安全性和有效性测试,公司官员尚未对进展发表评论。
尽管再生医学的终点比以往任何时候都更近,但新的挑战可能仍会出现。其中之一是确保在生长所需组织和过度刺激细胞之间找到平衡点,过度刺激细胞可能导致癌症。“未来的真正挑战是试图弄清楚何时、何地以及多大程度上激活这些通路,以增强修复而不引发意外后果,” 耶鲁大学的乔乔利说。到目前为止,科学家们对小规模安全性研究和默里的猪研究中未出现这一问题感到鼓舞,后者发现心脏或其他器官中没有异常细胞。
斯克里普斯研究所化学副教授迈克.博隆(Mike Bollong)说,经过数十年的实验,也许很快就有可能以一种让患者重获优质生活的方式修复受损器官。“这正是再生医学的意义所在。”
